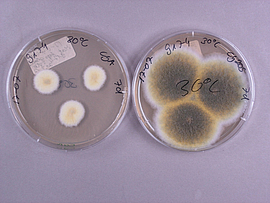
Zwei Petrischalen mit einer Schimmelpilzreinkultur.
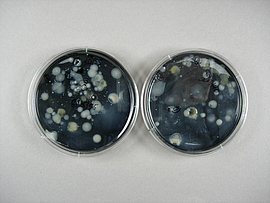
In zwei Petrischalen werden Wasserproben aus einer Verdunstungskühlanlage auf Legionellen untersucht.

Man kann sie erstmal nicht sehen, nicht hören, nicht riechen und nicht schmecken, trotzdem sind sie überall – ein breit gefächertes Spektrum an Mikroorganismen, wie Bakterien, Hefen und Schimmelpilze sowie deren Stoffwechsel- und Zerfallsprodukte (z. B. Mykotoxine und Endotoxine) sind Teil unserer Umwelt.
Mikroorganismen werden bei der Lebensmittelproduktion bei bestimmten Herstellungsverfahren gezielt eingesetzt (z. B. alkoholische Gärung, Starterkulturen für Käse oder Edelschimmel bei der Salamiherstellung). Oder die Beschäftigten kommen unabsichtlich mit Biostoffen in Berührung, z. B. bei Schlachtvorgängen von Tieren oder bei der Vorbereitung von Primärprodukten.
Um eine Wirkung auf den Menschen zu haben, braucht es in der Regel größere Mengen an Mikroorganismen. Diese Mengen sind entweder produktionsbedingt / verfahrensbedingt vorhanden, oder werden über längere Zeit durch Wachstum unter günstigen Bedingungen z. B. in den Produktionsstätten oder Innenräumen erreicht.
Kommt es zu gesundheitlichen Beschwerden, muss man sich damit befassen, ob eine Belastung durch diese Biostoffe am Arbeitsplatz vorliegt.
Unsere Dienstleistungen zur Erfassung von Biostoffen am Arbeitsplatz
Der Fachbereich Mikrobiologie / Betriebshygiene des Zentrallabors der BGN bietet umfangreiche Hilfen und Angebote bezüglich der Erfassung von Biostoffen an Arbeitsplätzen an, z. B.:
- Messung und Bewertung von Biostoffen am Arbeitsplatz mit akkreditierten Verfahren
- Anlage zur Teil-Akkreditierungsurkunde D-PL-14073-01-01
Deutsche Akkreditierungsstelle GmbH | PDF-Datei - Anlage zur Teil-Akkreditierungsurkunde D-PL-14073-01-02
Deutsche Akkreditierungsstelle GmbH | PDF-Datei - DAkkS-Liste Prüfverfahren im flexiblen Bereich
PDF-Datei
- Anlage zur Teil-Akkreditierungsurkunde D-PL-14073-01-01
- Beratung und Hilfestellung zu Gefährdungsbeurteilung
- Beratung zu Hygienefragen und Hygienekontrolle
- Mikrobiologische Trinkwasseruntersuchungen (Probenahme und Analytik – nach § 15 Abs. 4 der Trinkwasserverordnung anerkannte Untersuchungsstelle)
- Akkreditierte Untersuchung auf Legionellen und Gesamtkoloniezahl in Verdunstungskühlanlagen und Nassabscheidern nach ISO 11731 und UBA-Empfehlung

Blick in das Labor Mikrobiologie und Betriebshygiene des BGN Zentrallabors.
© BGN / Elke Danhamer
Unsere Leistungen im Detail
Mit unseren verschiedenen Messgeräten können wir Anfragen unserer Aufsichtspersonen oder der Mitgliedsbetriebe bearbeiten und führen die nötigen Messungen vor Ort und die anschließenden Analysen bei uns im Labor durch.

-
Verfahren zur Bestimmung der Schimmelkonzentration in der Luft am Arbeitsplatz (IFA Arbeitsmappe 9420:2003-04)
-
Verfahren zur Bestimmung der Bakterienkonzentration in der Luft am Arbeitsplatz (IFA Arbeitsmappe 9430:2004-04)
-
Verfahren zur Bestimmung der Endotoxinkonzentration in der Luft am Arbeitsplatz (IFA Arbeitsmappe 9450:2002-04)
-
Innenraumluftverunreinigungen - Nachweis und Zählung von Schimmelpilzen in Innenräumen – Probenahme durch Filtration (DIN EN ISO 16000-16:2009-12)
-
Innenraumluftverunreinigungen - Nachweis und Zählung von Schimmelpilzen in Innenräumen – Kultivierungsverfahren (DIN EN ISO 16000-17:2010-06)
-
Innenraumluftverunreinigungen - Nachweis und Zählung von Schimmelpilzen in Innenräumen – Probenahme durch Impaktion (DIN EN ISO 16000-18:2012-01)
-
Innenraumluftverunreinigungen - Nachweis und Zählung von Schimmelpilzen in Innenräumen – Probenahme von Materialien (DIN EN ISO 16000-21:2014-05)
-
Innenraumluftverunreinigungen - Bestimmung der Gesamtsporenzahl in Innenräumen (DIN EN ISO 16000-20:2015-11)
-
Akkreditierte Probenahme und Mikrobiologische Untersuchung nachfolgender Parameter aus Trinkwasser nach Trinkwasserverordnung
-
Gesamtkeimzahl bei 22 und 36°C
-
Legionellen
-
Escherichia coli und coliforme Bakterien
-
Enterokokken
-
Pseudomonas aeruginosa
-
Clostridium perfringens
-
-
Akkreditierte Untersuchung auf Legionellen und Gesamtkoloniezahl in Verdunstungskühlanlagen und Nassabscheidern nach ISO 11731 und UBA-Empfehlung
-
Beprobung von Oberflächen mittels Abklatsche und Tupfer
-
Nachweis von ATP auf Oberflächen zur Hygienekontrolle
-
Oberflächenproben und Luftmessungen nach VDI 6022 Blatt 1 (Hygieneanforderungen an Raumlufttechnische Anlagen)
-
Hemmwirkung von antimikrobiellen Materialien
Sie haben weitere Anliegen oder Untersuchungswünsche? Sprechen Sie uns an!
BGN Fachseminar Betriebshygiene für mittelgroße Betriebe in der Lebensmittelherstellung und der Gastronomie
In Lebensmittelbetrieben bzw. in lebensmittelverarbeitenden Bereichen hat die Einhaltung von Hygiene oberste Priorität. Um den Beschäftigten aufzuzeigen, welche Maßnahmen, Gesetze oder Methoden hierbei von Bedeutung sind, bieten wir zwei Mal jährlich ein Hygieneseminar für mittelgroße Betriebe in der Lebensmittelherstellung und der Gastronomie an. In diesem Seminar lernen die Teilnehmer durch Teamarbeit, spannende Diskussionen oder Anschauungsmaterialien, worauf es in der Lebensmittelhygiene ankommt.

